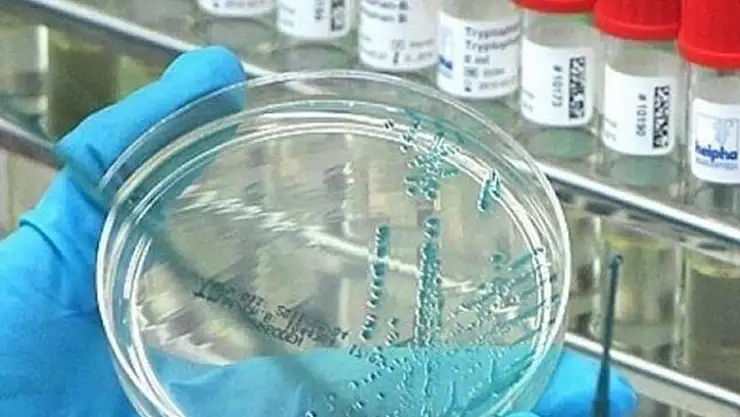

- Haberler
- 'Swine flu' leaves 5 dead in Morocco: Health minister
'Swine flu' leaves 5 dead in Morocco: Health minister
Officials 'closely monitoring' situation, health minister says
At least five people have died in Morocco after contracting H1N1, otherwise known as “swine flu”, the state-run Moroccan Press Agency reported Thursday.
“Five deaths have been reported so far from H1N1 at both public and private clinics,” the news agency quoted Health Minister Anas Doukkali as saying.
“H1N1 is the dominant flu subtype this year,” Doukkali added, going on to assert that his ministry was “closely monitoring” the situation.
The “swine flu” made international headlines in 2009 when the World Health Organization described its sudden appearance as a “pandemic”.